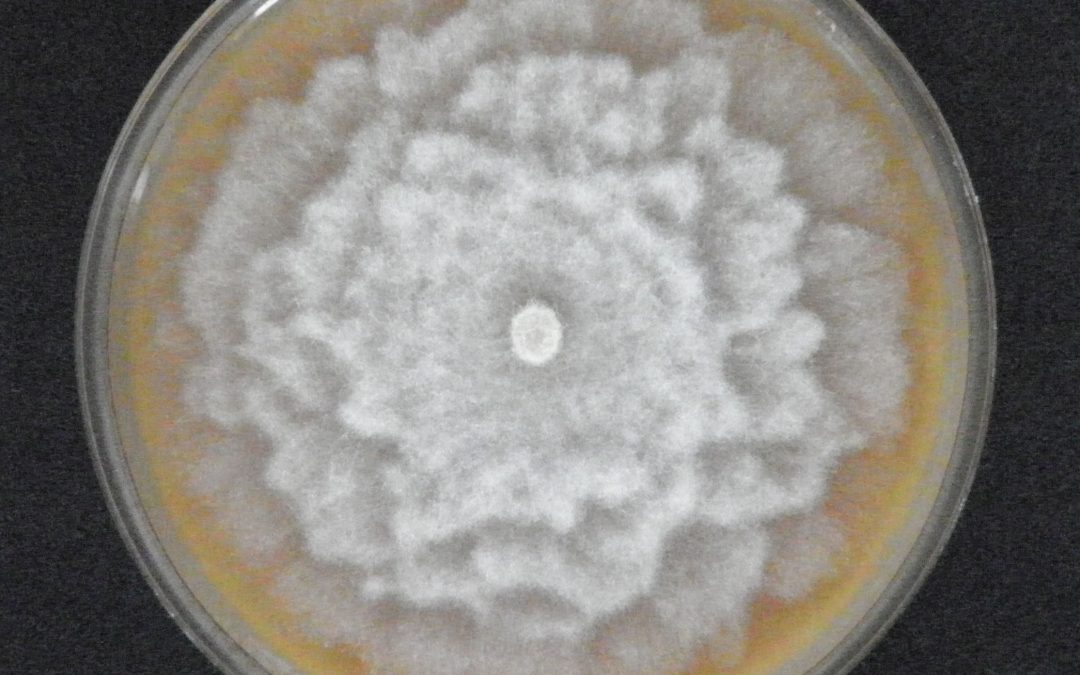
Účastníme se projektu EUPHRESCO!

autor: Admin Vukoz | Srp 21, 2025 | Aktuality, Aktuality biologická rizika
Publikace metody k odlišení topolu černého pro jeho záchranu v české krajině Výzkumníci z Odboru biologických rizik a Odboru rostlinných biotechnologií VÚK publikovali metodu k odlišení topolu černého (Populus nigra), původního druhu typického pro českou krajinu, od...

autor: Admin Vukoz | Srp 20, 2025 | Aktuality, Aktuality biologická rizika, Aktuality ekologie lesa
Nové projekty VÚK v Národním programu Životní prostředí Výzkumný ústav pro krajinu, v. v. i. je příjemcem dotace poskytnuté rozhodnutím ministra životního prostředí z Národního programu Životní prostředí, v rámci výzvy č. 2/2025 Monitoring složek životního prostředí,...

autor: Admin Vukoz | Pro 17, 2024 | Aktuality, Aktuality biologická rizika
Metodika identifikace topolu černého pomocí DNA markerů Ministerstvem zemědělství byla certifikována Metodika identifikace topolu černého pomocí DNA markerů, která je výsledkem řešení výzkumného projektu QK22010142, s názvem Záchrana populace topolu černého a jeho...

autor: Admin Vukoz | Čvc 10, 2024 | Aktuality, Aktuality biologická rizika, Aktuality fytoenergetika
VÚKOZ reprezentován na mezinárodní konferenci IUFRO ve Stockholmu V týdnu 24.-28.6.2024 se uskutečnil 26th IUFRO World Congress – Forest and Society Towards 2050 ve Stockholmu. Na této mezinárodní konferenci bylo 4271 odborníků z více než 100 zemí a prezentováno...

autor: Admin Vukoz | Čvc 26, 2023 | Aktuality, Aktuality biologická rizika
Účastníme se projektu EUPHRESCO! VÚKOZ se zapojil do projektu PHYTO-GARD Phytophthora in public gardens: understanding pathways and mitigating risk, v rámci sítě mezinárodní spolupráce fytosanitárního výzkumu v Evropě EUPHRESCO. Téma: Phytophthora ve veřejných...

autor: Admin Vukoz | Kvě 3, 2023 | Aktuality, Aktuality biologická rizika
Nové stránky o invazních patogenech Jednou z největších výzev v ochraně přírody a krajiny je šíření nepůvodních druhů organismů. Významnou, ale prozatím málo probádanou skupinou invazních organismů jsou houby a oomycety, mezi nimiž najdeme srovnatelně významné druhy...